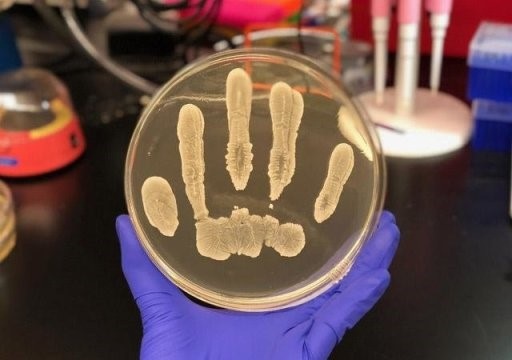
Vi khuẩn có lợi trên da phòng chống ung thư da - 1 Vi khuẩn có lợi trên da phòng chống ung thư da - 1

Vi khuẩn có lợi trên da phòng chống ung thư da
(Dân trí) - Các nhà nghiên cứu tại trường Y, Đại học California đã phát hiện ra vai trò mới tiềm năng của một số vi khuẩn trên da, đó là khả năng bảo vệ chống ung thư.
GS. Richard Gallo, đồng tác giả nghiên cứu cho biết: “Chúng tôi đã xác định được chủng khuẩn Staphylococcus epidermidis xuất hiện phổ biến trên da người khỏe mạnh với khả năng ức chế sự phát triển của một số bệnh ung thư. Chủng khuẩn độc nhất trên da này sản sinh hóa chất tiêu diệt một số loại tế bào ung thư mà lại không gây độc cho các tế bào bình thường”.
Nhóm nghiên cứu đã phát hiện ra rằng chủng khuẩn S.epidermidis sản sinh hóa chất 6-N-hydroxyaminopurine (6-HAP). Sau khi được cho tiếp xúc với tia cực tím gây ung thư, chuột có S.epidermidis trên da nhưng không tiết ra 6-HAP, sẽ có nhiều khối u xuất hiện trên da, trong khi đó chuột có S.epidermidis trên da sản sinh 6-HAP không hề có khối u nào. 6-HAP là phân tử làm suy yếu sự hình thành của ADN, được gọi là sự tổng hợp ADN và ngăn chặn sự lan rộng của các tế bào khối u biến đổi cũng như có tiềm năng cản trở sự phát triển của ung thư da do tia cực tím.
Chuột được tiêm tĩnh mạch hóa chất 6-HAP cứ 48 tiếng một lần trong thời gian hơn 2 tuần, không thể hiện ảnh hưởng bị nhiễm độc rõ ràng, nhưng khi được cấy ghép tế bào ác tính, kích thước khối u của chuột đã giảm hơn 50% so với nhóm đối chứng.
GS. Gallo cho biết: “Ngày càng có nhiều bằng chứng cho thấy hệ vi khuẩn trên da là một yếu tố quan trọng đối với sức khỏe con người. Trước đây, chúng tôi đã phát hiện ra một số vi khuẩn trên da người sản sinh các peptit kháng khuẩn bảo vệ con người khỏi vi khuẩn gây bệnh như Staph aureus”.
Trong trường hợp của S. epidermidis, vi khuẩn này xem ra cũng bổ sung một lớp bảo vệ chống một vài dạng ung thư. Tuy nhiên, cần thực hiện các nghiên cứu chuyên sâu để tìm hiểu phương thức 6-HAP được sản sinh, xem xét khả năng sử dụng hợp chất này để ngăn chặn ung thư hoặc nguy cơ ung thư có tăng hay không 6-HAP bị mất.
Mỗi năm ở Hoa Kỳ có hơn 1 triệu trường hợp ung thư da được chẩn đoán. Hơn 95% số ca này là ung thư da không phải dạng u hắc tố, mà nguyên nhân thường là do tiếp xúc quá nhiều với tia cực tím từ mặt trời. U hắc tố là dạng ung thư da nghiêm trọng nhất khởi phát trong các tế bào da sản sinh hắc tố được gọi là tế bào hắc tố.
N.P.D-NASATI (Theo Medicalxpress)










